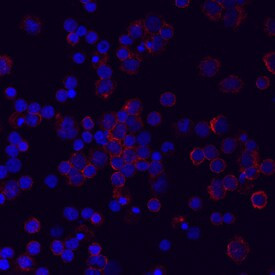
LILRA5 Antibody in Immunocytochemistry (ICC/IF)

Search
Invitrogen
LILRA5 Monoclonal Antibody (711828)
{{$productOrderCtrl.translations['antibody.pdp.commerceCard.promotion.promotions']}}
{{$productOrderCtrl.translations['antibody.pdp.commerceCard.promotion.viewpromo']}}
{{$productOrderCtrl.translations['antibody.pdp.commerceCard.promotion.promocode']}}: {{promo.promoCode}} {{promo.promoTitle}} {{promo.promoDescription}}. {{$productOrderCtrl.translations['antibody.pdp.commerceCard.promotion.learnmore']}}
图: 1 / 2
LILRA5 Antibody (MA5-24330) in ICC/IF


产品信息
MA5-24330
种属反应
宿主/亚型
分类
类型
克隆号
抗原
偶联物
形式
浓度
规格
纯化类型
保存液
内含物
保存条件
运输条件
RRID
产品详细信息
In direct ELISAs, no cross-reactivity with recombinant mouse ILT11/LILRA5, recombinant rat (rr) ILT11/LILRA5, rrLILRC2, recombinant human (rh) ILT4/CD85d, rhILT5/CD85a, or rhILT3/CD85k is observed.
Reconstitute in sterile PBS to a final concentration of 0.5 mg/mL.
靶标信息
Leukocyte immunoglobulin-like receptor A5 (LILRA5) is a gene located on chromosome 19q13.42, encoding a protein that is part of the leukocyte immunoglobulin-like receptor (LILR) family. These receptors are primarily expressed on immune cells, such as natural killer cells, monocytes, and dendritic cells, and play a pivotal role in modulating immune responses. LILRA5 is thought to function as an activating receptor, influencing the activation and regulation of immune cell functions. It is implicated in processes such as antigen presentation, cytokine production, and phagocytosis, contributing to both innate and adaptive immune responses. Dysregulation of LILRA5 expression or function can impact immune homeostasis and has been associated with various autoimmune and inflammatory diseases. Research into LILRA5 aims to uncover its specific ligands and signaling pathways, with potential implications for therapeutic targeting in immune-related disorders.
仅用于科研。不用于诊断过程。未经明确授权不得转售。
篇参考文献 (0)
生物信息学
蛋白别名: CD85 antigen-like family member F; CD85f; CD85f antigen; ILT-11; immunoglobulin superfamily; immunoglobulin superfamily receptor; Immunoglobulin-like transcript 11; immunoglobulin-like transcript 11 protein; leucocyte Ig-like receptor A5; leukocyte Ig-like receptor 9; Leukocyte immunoglobulin-like receptor 9; Leukocyte immunoglobulin-like receptor subfamily A member 5; leukocyte immunoglobulin-like receptor subfamily A member 5 soluble; leukocyte immunoglobulin-like receptor, subfamily A (with TM domain), member 5; leukocyte immunoglobulin-like receptor, subfamily B (with TM and ITIM domains), member 7; LIR-9; LIR-family activating receptor 9m1; LIR-family activating receptor 9m2; LIR-family secreted receptor 9s1; LIR-family secreted receptor 9s2
基因别名: CD85; CD85F; ILT-11; ILT11; LILRA5; LILRB7; LIR-9; LIR9
UniProt ID: (Human) A6NI73
Entrez Gene ID: (Human) 353514